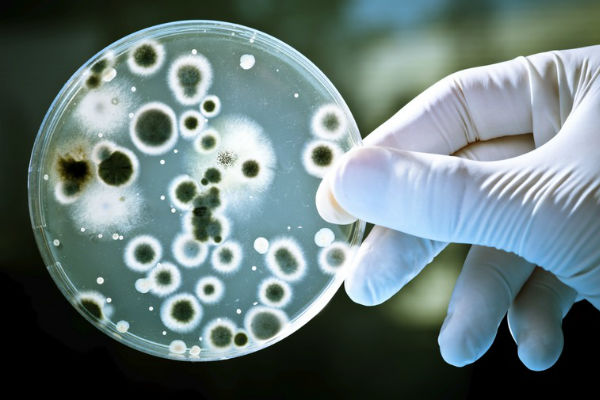

U desecima laboratorija diljem svijeta očajnički se traga za novom generacijom antibiotika koja bi mogla zaustaviti katastrofu koja se sprema, no još nema rezultata.
U samo nekoliko dana koliko je trebalo da se razvije groznica, Josip je izgubio gotovo petinu kilaže. Nakon što je negdje, najvjerojatnije u autobusu dok se vozio s posla kući, pokupio bakteriju, ono što se u prvi trenutak činilo kao obična gripa preraslo je u vrlo snažnu upalu pluća, a sada su i organi počeli otkazivati… Liječnici su stvar pokušali sanirati antibioticima, ali bez uspjeha. Zahvatila ga je bakterija otporna na ove lijekove, i sve što je sada moguće je nadati se najboljem. No nada je vrlo krhka..
Ovo je scenarij koji bi se uskoro mogao događati u hrvatskim, ali i europskim bolnicama. Nije stvar u neodržavanju higijene, lošoj zdravstvenoj tehnologiji, klimavom znanju, već problem leži u činjenici da su bakterije na postojeće antibiotike postale otporne. Ono što je prije samo nekoliko godina bilo nezamislivo, postaje stvarnost s kojom ćemo se uskoro morati suočiti. Stvarnost u kojoj ćemo za nekoliko godina početi umirati i od banalnih ozljeda, uboda na zahrđali čavao, od obične posjekline. Rutinske operacije poput operacije slijepog crijeva postat će noćna mora zbog učestalih infekcija, dok na transplantaciju organa možemo zaboraviti. Da bi se presadio organ, potrebno je srušiti prirodni imunitet pacijenta kako tijelo ne bi odbacilo donirani organ, ali ga je ujedno nužno zaštititi od infekcija antibioticima. Sada ti antibiotici postaju potpuno neučinkoviti. Ovo je prikrivena noćna mora s kojom se EU pokušava nositi već godinama, s upitnim uspjehom. Posljednja generacija antibiotika, među kojima je i Plivin Sumamed, razvijena je prije tridesetak godina, a novih vrsta antibiotika nema na vidiku.
Pacijenti ih sami traže
U ovome trenutku pokušava se smanjiti izdavanje i uporaba antibiotika na najmanju moguću mjeru kako bi se što dulje zadržao njihov medicinski potencijal. Naime, upravo zato što se za antibioticima već godinama olako poseže, zbog njihove sveprisutnosti, bakterije razvijaju otpornost, svojevrsni imunitet na postojeće antibiotike. Smanjiti količinu antibiotika u okolišu jedina je mogućnost usporavanja bakterija u potpunom razvoju imuniteta na lijekove. – Problem je u tome što su hrvatski i europski pacijenti jednostavno naučeni na antibiotike, a liječnici ih prepisuju i za najjednostavnije bolesti, čak i tamo gdje potrebe za antibioticima jednostavno nema jer nisu u takvim slučajevima djelotvorni.
Pacijenti nerijetko dolaze k liječnicima zahtijevajući da im se izdaju antibiotici, ne želeći otići iz ordinacije dok ne dobiju recept. I često u tome uspijevaju. Na sreću, ovakva je praksa ipak sve rjeđa jer su liječnici svjesni problema koji se nalaze pred nama – kaže jedan od liječnika opće medicine u Zagrebu. Situacija je toliko teška i zabrinjavajuća da je EU još prije desetak godina, predviđajući ovakav razvoj događaja, postavio borbu protiv otpornosti na antibiotike kao svoj vodeći cilj u zdravstvu. U to vrijeme malo je tko izvan zdravstvenih krugova bio uopće svjestan kakva se potencijalna katastrofa sprema, no to je sada vrlo bliska i izvjesna opasnost.
Slijedi zastrašujuća budućnost. Budućnost u kojoj će rutinske operacije, porođaji, upale pluća, pa čak i kožne infekcije postati smrtonosne. Ovo je problem koji ne poznaje granice, koji moramo rješavati zajedno, na razini Europske unije i svijeta, svi skupa. No rezultati su zabrinjavajući jer smo, u razdoblju od 2013. do 2016., a to su posljednji podaci, vidjeli golem porast bakterija otpornih na antibiotike – rekao je za “Večernji list” Vytenis Andriukaitis, povjerenik Europske komisije za zdravstvo. A ti podaci pokazuju i da je Hrvatska u prilično nepovoljnim položaju. Posebno je to izraženo u slučaju bakterije Acinetobactera, uzročnika upale pluća i infekcija krvožilnog sustava. Ova bakterija upravo na području Hrvatske, ali i Italije, Grčke, Bugarske, Rumunjske i Mađarske, razvija žestoku otpornost na antibiotike i upravo se protiv infekcija nastalih ovom bakterijom liječnici sve teže bore. Možda zvuči čudno, no većinu antibiotika na kojima bakterije stječu otpornost ne dolazi samo iz zdravstva već i iz poljoprivrede. Naime, antibiotici se već desetljećima vrlo neselektivno koriste u stočarstvu kako bi se poboljšali rezultati tova, a životinje preventivno “pokrile” pred bolestima. Antibiotici se miješaju u krmne smjese još u tvornicama stočne hrane prije nego što su uopće došle do životinja kojima su namijenjene. Kako je riječ o preventivnim, malim količinama antibiotika, one predstavljaju savršen poligon bakterijama za stjecanje otpornosti. Ujedno, ove blage količine antibiotika završavaju u mesu životinja, u mlijeku, jajima koje svakodnevno jedemo, čime bakterije dobivaju dodatna mjesta za “čeličenje”. Svemu tome treba dodati i okoliš, u kojemu završava otpad s farmi pun niskih doza antibiotika.
Šteta je učinjena – U takvom okruženju pravo je čudo da se otpornost bakterija na antibiotike nije i ranije i brže počela razvijati. Antibiotici se sada manje koriste u stočarstvu nego prije nekoliko godina, no šteta je već uvelike načinjena – kaže dr Ivan Carević.
Europska unija već neko vrijeme razvija modele sprečavanja prekomjerne uporabe antibiotika, a u radne skupine okuplja stotine liječnika, mikrobiologa, farmaceuta i veterinara kako bi osmislili učinkovit način suzbijanja infekcija bakterijama otpornim na antibiotike. Upravo je prije nekoliko dana, tijekom Antibiotici awareness, predstavljen i novi sustav nazvan One health, kojim bi se pokušalo, s vremenom, suzbiti ovaj problem. A ovaj je sustav doista golem. Obuhvaća Europsku agenciju za hranu, Europski centar za kontrolu i prevenciju bolesti, Europsku agenciju za lijekove, te Europsku agenciju za okoliš.
Ideja je da ovaj sustav prati, provjerava i reagira na terenu diljem cijele Europske unije kako bi se smanjila uporaba antibiotika na svim razinama. Ujedno, pokušava se u farmaceutskoj industriji stimulirati razvoj novih vrsta antibiotika na koje bakterije još nisu stekle otpornost, ali i niz drugih mjera poput razvoja novih cjepiva kojima se infekcije mogu spriječiti. Tu je i razvoj novih, suvremenijih i boljih načina dijagnoze infekcija, ali i rad na edukaciji poljoprivrednika te uvođenju naprednih stočarskih sustava koji ne uključuju uporabu antibiotika.
– Iako vidimo već na početku blagi napredak, trebat će učiniti još puno toga da bi stanje bilo pod kakvom-takvom kontrolom, da bi se otpornost bakterija na antibiotike smanjila na prihvatljivu razinu. Zasad otpornost bakterija, pogotovo sojeva Acinetobacter i Escherichia coli raste, i to na području cijele Europe. Pacijenti zaraženi ovim bakterijama imaju danas vrlo ograničene mogućnosti liječenja – kaže Andrea Ammon, direktorica Europskog centra za kontrolu i prevenciju bolesti.
Još prije dvadesetak godina smatralo se kako će nove, učinkovitije generacije antibiotika dolaziti redovito na tržište, no to je bila kriva procjena. Naime, razvoj antibiotika nije samo vrlo složen već i vrlo skup proces za koji farmaceutske kompanije godinama nisu imale nikakvog interesa. Jer dok lijekove za srčane bolesti ili dijabetes pacijenti piju cijelog života, liječenje antibioticima traje po nekoliko dana, a isplativost njihova razvoja prilično je upitna. Takvo, isključivo komercijalno razmišljanje sada dolazi na naplatu i obija se cijelom čovječanstvu o glavu.
U desecima laboratorija diljem svijeta očajnički se traga za novom generacijom antibiotika koja bi mogla zaustaviti katastrofu koja se sprema, no još nema rezultata. Sve se češće pojavljuju i prilično radikalna rješenja koja bi mogla, ako ne zamijeniti, a ono bar nadopuniti postojeće antibiotike čija učinkovitost sve više pada. Zasad postoje dva modela tih alternativnih načina borbe protiv bakterijskih infekcija. Prva od njih je serumska terapija koju tvore antitijela. Ova je terapija razvijana do 1925. godine kada je pojavom tada novih antibiotika napuštena. Inače, tvorac serumske terapije Emil von Behring za svoje je otkriće dobio i Nobelovu nagradu, a njegove se ideje i rješenja počinju sada ponovno koristiti.
Drugi obećavajući način liječenja uporaba je bakteriofaga, virusa koji napadaju bakterije. Ovu tehniku svojedobno su razvili istočnoeuropski liječnici, a posebno se često koristi na području Gruzije. Ove dvije tehnike, gotovo napuštene otkad je počela masovna uporaba antibiotika, danas su ponovo pod povećalom stručne javnosti i liječnika, i trenutačno su najveća nada u sprečavanju zdravstvene katastrofe i urušavanja modela liječenja. Nada da će pokriti zdravstvo bar dok farmaceutska industrija ne razvije novu generaciju antibiotika. – Nitko ne zna što će se događati sljedećih godina, do koje ćemo mjere uspjeti zadržati učinkovitost antibiotika, koliko ćemo smanjiti njihovu uporabu bez prijeke potrebe. Teško je reći i kako će se otpornost bakterija na antibiotike razvijati, i koliko nam alternativne metode liječenja mogu pomoći. No jedno je sigurno, treba što prije nešto učiniti, zaustaviti ovakav trend jer je cijelo čovječanstvo pred opasnošću kakve većina nije uopće svjesna – kaže infektologija Gabrijela Denatti.